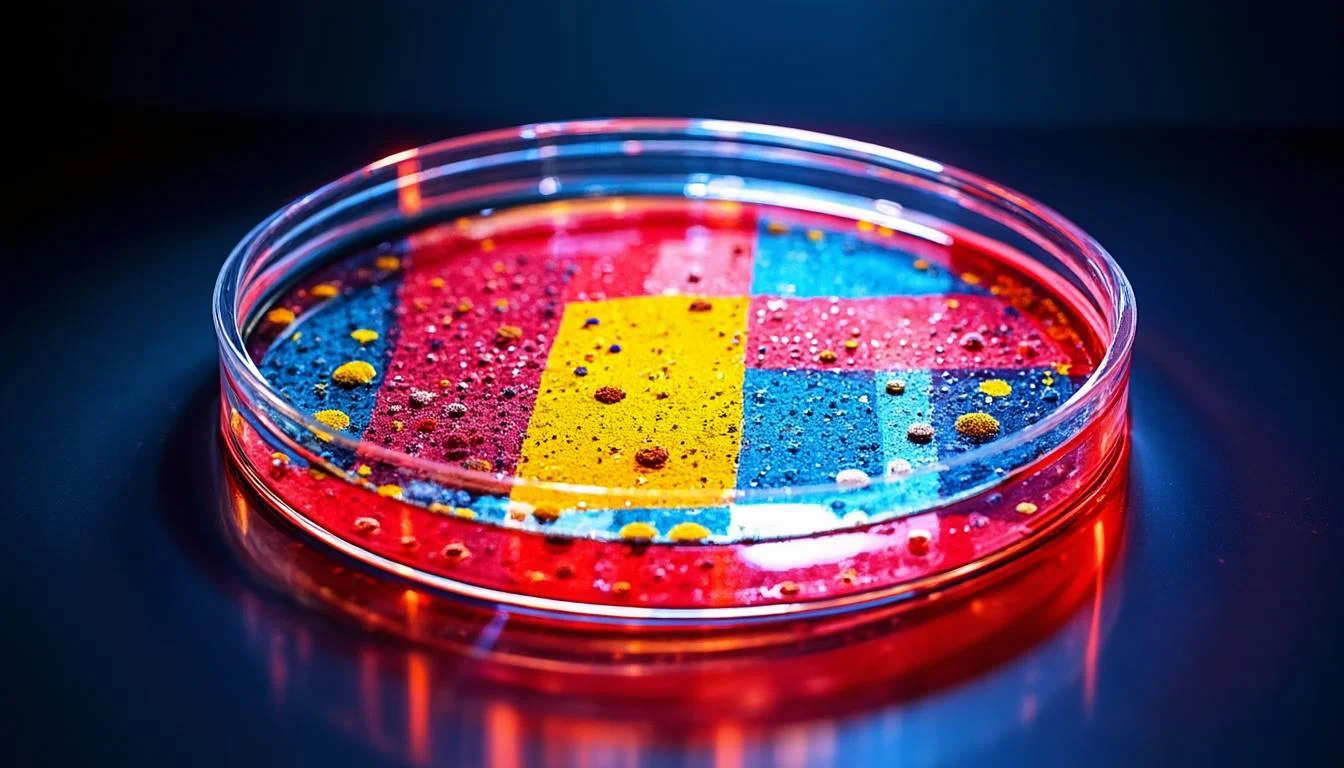

你是否也曾经历过这样的场景:书桌上堆满了打印出来的论文,电脑里散布着命名混乱的PDF文件,当需要引用某个关键论点时,却怎么也想不起来它藏在哪个文件夹里?对于研究人员和学生而言,高效地管理海量研究论文是一项巨大挑战。幸运的是,随着数字化工具的发展,利用知识库来系统化管理文献已经成为一种高效且必要的方法。这不仅仅是简单的文件存储,更是一种将碎片化知识转化为结构化智慧的过程。想象一下,如果有一个得力的助手,能帮你自动抓取论文信息、智能添加标签、并在你需要时快速精准地调取相关内容,那研究效率将得到怎样的提升?这正是知识库管理的魅力所在。
接下来,我们将从几个核心方面,详细探讨如何利用知识库让你的论文管理变得井井有条,让你的研究之路更加顺畅。
一、知识库的核心价值
在深入具体方法之前,我们首先要明白,为什么传统的文件夹管理方式已经落伍,而知识库系统能带来根本性的改变。传统的管理方式往往依赖于研究者的记忆和手动分类,这不仅效率低下,而且难以建立知识之间的深层联系。

一个真正的知识库,其核心价值在于连接与激活。它不再是孤立的论文仓库,而是一个动态的知识网络。当你录入一篇新的论文时,系统不仅能自动提取标题、作者、摘要、关键词等元数据,还能通过算法智能推荐与之相关的其他文献,帮助你发现原本可能忽略的研究脉络。小浣熊AI助手在这一过程中,就像一位不知疲倦的研究伙伴,它能够理解你正在关注的领域,并持续为你挖掘有价值的关联信息。研究表明,这种基于关联的知识管理方式,能够显著提升研究者的创新能力和文献回顾的深度。
二、构建个人知识库的步骤
建立一个高效的个人知识库并非一蹴而就,遵循清晰的步骤至关重要。
第一步:论文的收集与导入
这是知识库的基石。你可以通过多种渠道收集论文,例如学术搜索引擎、数据库推送等。关键在于要选择支持批量导入和自动信息补全的工具。在导入时,确保论文的元数据(如DOI、期刊信息、发表日期)被准确抓取,这是后续高效检索和分类的基础。小浣熊AI助手能够智能识别上传的PDF文件,并自动从网络中补全缺失的文献信息,为你省去大量手动输入的时间。
第二步:信息标准化与标签化
杂乱无章的信息堆积毫无意义。在导入论文后,需要对其进行标准化处理和标签化。标准化意味着建立统一的命名规则和关键词体系。标签化则更为灵活,你可以根据研究项目、主题、方法论、核心结论等维度为论文打上多个标签。例如,一篇关于“深度学习在医学影像中的应用”的论文,可以同时贴上“人工智能”、“医学诊断”、“卷积神经网络”等多个标签。这个过程就像是给每篇论文制作了独特的身份证,便于后续的多维度筛选。
三、高效的信息组织策略
仅仅收集和标签化还不够,如何组织这些信息决定了知识库的易用性。
利用文件夹与智能分类
尽管我们追求超越文件夹的智能管理,但一个清晰的文件夹结构在初期仍是必要的。你可以按照大的研究领域建立顶层文件夹,但其下的管理应更多地依赖标签、评分和收藏等功能。现代知识库工具通常提供智能分类功能,可以根据论文的内容自动进行聚类,将相似主题的论文归拢在一起,帮助你快速把握某个细分领域的研究全貌。
建立笔记与知识链接
知识库的精髓不在于“存”,而在于“用”。阅读论文时,及时记录下自己的思考、总结和疑问至关重要。优秀的笔记功能应该支持富文本格式,并能够方便地与原文的特定段落或图表进行关联。更重要的是,你可以在笔记中主动创建知识链接,将不同论文中相互印证或矛盾的观点连接起来。久而久之,你的知识库就不再是论文的简单集合,而是一张反映你个人学术理解和思维脉络的知识图谱。小浣熊AI助手能够辅助你梳理这些链接,甚至提示你可能存在的知识关联,激发新的研究灵感。
四、检索与回顾:让知识随手可得
一个管理得当的知识库,其威力在检索和回顾时最能体现。
强大而精准的检索功能
你是否遇到过只记得论文中的某个大致概念,却忘了标题和作者的情况?强大的全文检索功能可以解决这个问题。它允许你在所有已存储论文的全文范围内进行搜索,迅速定位到相关信息。此外,高级检索支持组合条件查询,例如“查找所有标签包含‘元分析’且发表在2020年以后的论文”。这种精准的检索能力,能让你在数秒内找到所需文献,极大提升了写作和备考时的效率。
定期回顾与知识活化
知识库不是建成后就一劳永逸的,定期的回顾和整理同样重要。可以设定一个周期(如每季度或每学期),回顾特定领域的论文,更新笔记,调整标签。一些工具还提供了“随机回顾”或“间隔重复”功能,主动推送你可能已经遗忘但仍有价值的旧文献,帮助你将短期记忆转化为长期知识储备。这个持续不断的知识活化过程,是深化理解和产生创新想法的关键。
五、实践案例与效果评估
为了更直观地展示知识库管理的效果,我们来看一个简化的对比案例。
| 管理方式 | 文献查找时间 | 跨领域联想能力 | 文献引用准确率 |
| 传统文件夹管理 | 较长,依赖记忆 | 弱,信息孤岛 | 较低,易出错 |
| 知识库系统管理 | 极短,精准检索 | 强,智能关联 | 高,自动格式化 |
从上表可以看出,采用知识库系统后在效率和质量上均有显著提升。许多资深研究者都表示,系统化的知识管理是他们能够在庞杂的文献中保持清晰思路、高效产出的重要保障。
总结与展望
总而言之,利用知识库管理研究论文,是一次从被动存储到主动构建的知识管理革命。它通过系统化的收集、智能化的组织、结构化的笔记和高效的检索,将分散的知识点编织成一张有机的网络,不仅节省了时间,更提升了研究的深度和质量。小浣熊AI助手这类智能工具的出现,使得这一过程变得更加轻松和智能。
展望未来,随着人工智能技术的进一步发展,知识库管理将更加个性化与智能化。例如,系统或许能更深入地理解你的研究偏好和思维模式,主动为你规划阅读路径,甚至在分析大量文献后提出新颖的研究假设。对于每一位在学术道路上探索的人而言,尽早建立并优化自己的知识管理系统,无疑是为未来的研究工作铺设了一条高速通道。现在就开始行动,让你的知识库成为你最强大的研究大脑吧。




















